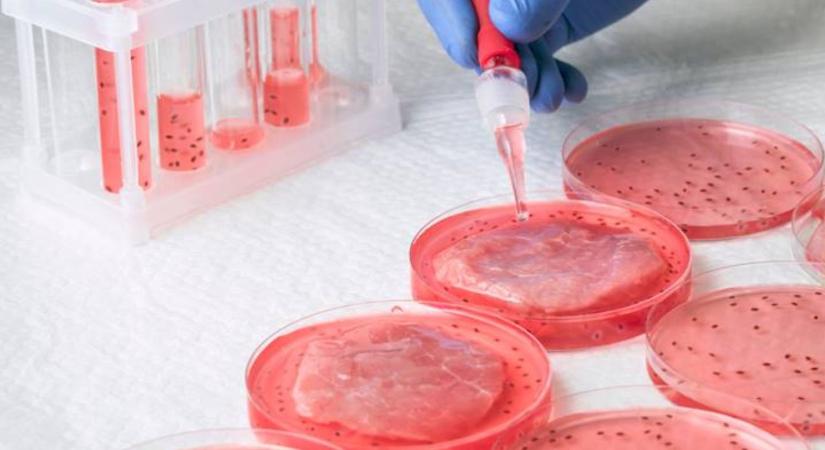
Műhús? Köszönjük, nem kérünk belőle

Műhús? Köszönjük, nem kérünk belőle
Az agrárminiszter úgy látja, az élővilág és a gazdák munkája valódi érték, amit nem helyettesíthet laboratóriumi technológia. A hazai szabályozás ennek szellemében született meg.
Hamarosan átirányítunk a teljes cikkhez → Agroinform